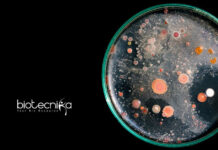
NIT Rourkela MSc & MTech Life Sciences Research Fellow Job NIT Rourkela MSc

New Study Indicates Depression May Alter Brain Structure
White matters
Statistics related to depression is overwhelming- 350 million people suffer from it, and 800,000 of them end their own lives every year as...
Cellectis Biotech Gets CRISPR Patent, To Leverage CAR-T Therapies for Cancer
Cellectis has now announced that the European Patent Office has granted it a patent to use CRISPR in T cells in order to enable...
Rodeo Therapeutics Raises $5.9M In Series A Financing For Its Regenerative Studies
Seattle-based biotech startup, Rodeo Therapeutics, working on tissue regeneration has now reportedly raised $5.9 million in a series A financing round with a list of...
Health Ministry Issues Notices To Hospitals on Capping Stent Prices
In a circular addressed to the health secretaries of all the states in the country, the Union Health Ministry has directed all hospitals, including...
Celgene Pays a Settlement of $280 Million To Resolve Fraud Suit
Celgene Corp. has agreed to pay $280 million to settle claims that it marketed the cancer drugs Thalomid and Revlimid for unapproved uses, the company said in...
Antabio Awarded $8.9M to Develop a Novel Cystic Fibrosis Antibiotic
French biotech, Antabio, a biopharmaceutical company developing novel antibacterial treatments in areas of highest unmet needs, has now received an award that will support the...
Acne Treatment with Gold Microparticle?! | Receives $36M Financing
Georgia-based biotech Sebacia, a privately held, clinical and commercial stage dermatology and aesthetics company, has now announced the completion of a $36 million funding intended...
Walk-In for Research Fellow Position @ ICAR – NDRI | Biotech & Biochem Candidates...
ICAR-NATIONAL DAIRY RESEARCH INSTITUTE
SOUTHERN REGIONAL STATION,
ADUGODI, HOSUR ROAD,
BENGALURU-560 030 (KARNATAKA)
Walk-in-Interview for the position of one Senior Research Fellow (SRF) in below mentioned project/scheme will...
Khorana Program for Scholars | B.Tech, M.Tech / B.Sc./ M.Sc Biotech Eligible
The Department of Biotechnology (DBT), Govt. of India, Indo-US Science and Technology Forum (IUSSTF) and WINStep Forward are partnering to support the prestigious Khorana...
Biotecnika Times – Newsletter 26.07.2017
Govt Job : Scientific Assistant Post @ SVP National Police Academy | Salary of Rs. 52,000/- p.m.
Applications are invited from eligible candidates for filling...
Gene Editing Helps Cure Cancer in Two Babies
In what’s being billed as a medical first, scientists at the Great Ormond Street Hospital in London have presented a hopeful solution to cancer by developing...
A Child Has Been Virtually Cured Of HIV Form Past 9 Years & Counting…...
HIV, which is known to affect more than 36.7 million people worldwide, is one of the deadliest viruses around today — since it was discovered, it’s...
Orchard Receives a FDA Go-Ahead For Its “Bubble Baby” Disease
Orchard Therapeutics is a clinical-stage biotechnology company dedicated to bringing transformative autologous ex-vivo gene therapies to patients with rare diseases. The biotech has now received rare...
Fighting Tropical Diseases With Biotech
While CRISPR, nanobots and transplants are making headlines as medical breakthroughs, a number of new technologies- the unsung heroes of medicine, are also making progress tackling some of the...
Cancer Biotech Raises $38.6M In SERIES C
eFFECTOR Therapeutics, a five-year-old cancer drug developer, has raised $38.6 million in venture capital funding, the San Diego biotech company said Monday.
The series C round was...